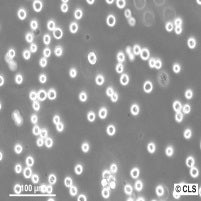
Colo-205

DMEM/F12 (1:1), w: L-Glutamine, w/o: Phenol red, w: 1.2 g/L NaHCO3
฿1,690.00

DMEM/F12 (1:1) w: L-Glu and Sodium Bicarb w/o: Phenol
Cat-no : P04-41650
Size: 500 ml
Store at: +2°C – +8°C
Sterile : Yes
HS-Code: 38210000
Availability: Green
Key Features of DMEM/F12 (1:1) with L-Glutamine, Without Phenol Red, and 1.2 g/L NaHCO3:
- L-Glutamine Enrichment: L-Glutamine is an essential amino acid for cell culture, contributing to the long-term health of your cells.
- Phenol Red-Free: The absence of Phenol Red eliminates potential interference in certain assays and experiments.
- Precise NaHCO3 Concentration: With 1.2 g/L NaHCO3, this medium provides an optimal environment for pH maintenance, promoting successful cell culture.
| Vendor | PAN Biotech |
|---|
Related products
฿1,190.00
Tissue Culture
฿1,190.00
Tissue Culture
฿1,190.00
Tissue Culture
฿1,990.00
฿3,790.00
Tissue Culture
฿1,790.00
Tissue Culture
฿29,090.00
฿1,690.00